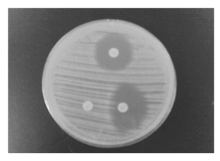

通讯作者:张珏,联系电话: 021-53827187。
作者简介:乔昀,女,1971年生,学士,副主任技师,主要从事微生物学检验工作。
了解金黄色葡萄球菌(SA)对红霉素和克林霉素的耐药性,检测红霉素对克林霉素诱导耐药的发生率及诱导耐药基因。
方法采用美国临床实验室标准化协会(CLSI)推荐的纸片扩散法,用头孢西丁纸片检测耐甲氧西林金黄色葡萄球菌(MRSA)并以红霉素、克林霉素双纸片法(D试验)分析红霉素对克林霉素诱导耐药表型,用聚合酶链反应(PCR)检测耐药基因。
结果146株SA中MRSA占57.5%。SA对红霉素及克林霉素同时耐药的有82株,占56.2%,红霉素耐药而克林霉素敏感或中介的有34株,其中D试验阳性26株,红霉素诱导克林霉素耐药率76.5%。红霉素耐药而克林霉素敏感或中介的MRSA和甲氧西林敏感金黄色葡萄球菌(MSSA)中D试验阳性分别为80.0%和71.4%。克林霉素耐药菌株主要由 erm 基因决定,结构型耐药菌株主要耐药基因为 ermA ,诱导型耐药菌株的主要耐药基因为 ermC。
结论临床微生物实验室应加强对SA中克林霉素诱导耐药的检测,以指导临床医师合理选用大环内酯类、林可酰胺类抗菌药物。
To investigate the resistance of Staphylococcus aureus(SA) to erythromycin and clindamycin, and to detect the incidence of clindamycin-induced resistance by erythromycin and the induction of resistance genes.
MethodsThe disk diffusion method recommended by the standards of Clinical and Laboratory Standards Institute (CLSI) was used,and cefoxitin disk diffusion test was used for the detection of meticillin-resistant Staphylococcus aureus (MRSA). The inducible resistance phenotype of erythromycin to clindamycin was analyzed by clindamycin and erythromycin double-disk diffusion method (D test), and the resistant gene was detected by polymerase chain reaction(PCR).
ResultsIn 146 strains of SA, MRSA accounted for 57.5%. SA resistant to both erythromycin and clindamycin were 82 strains, accounted for 56.2%. The erythromycin resistant and clindamycin susceptible or intermediate strains were 34 strains, which D test positive were 26 strains ,the percentage for inducible resistance of erythromycin to clindamycin was 76.5%.The positive rates of D test were 80.0% and 71.4% in erythromycin resistant and clindamycin susceptible or intermediate MRSA and methicillin-sensitive Staphylococcus aureus(MSSA). The predominant gene for clindamycin resistance was erm. The predominant gene for constitutive resistance to clindamycin was ermA. The predominant gene for inducible resistance to clindamycin was ermC.
ConclusionsThe detection of inducible clindamycin resistance in SA should be paid attention in clinical microbiology laboratories in order to guide physicians to select antimicrobial agents correctly such as macrolides and lincosamides.
金黄色葡萄球菌(SA)是医院和社区感染的重要病原菌。而耐甲氧西林的金黄色葡萄球菌(MRSA)往往又同时对β -内酰胺酶类抑制剂复合抗菌药物及碳青酶烯类耐药。因此, 临床医生常常使用大环内酯类(红霉素)、林可酰胺类(克林霉素)、B类链阳霉素类抗菌药物治疗MRSA引起的感染, 特别是克林霉素最常用于治疗皮肤或软组织的感染, 同时也是对青霉素和头孢菌素过敏患者感染治疗的首选[1]。红霉素具有诱导克林霉素耐药的作用。但由于目前临床实验室常用的药敏方法不能检测出克林霉素诱导型耐药, 导致克林霉素治疗无效[2]。本实验通过双纸片法(D试验)检测红霉素诱导克林霉素耐药情况, 通过聚合酶链反应(PCR)了解曙光医院SA中克林霉素耐药分子流行病学特征, 以指导临床医生合理使用抗菌药物。
1. 菌株 2010年6月至2011年4月曙光医院住院和门诊患者送检标本, 从同一患者同一部位多次分离的相同菌株按1次统计。分离的SA 146株, 其中痰标本44株, 脓标本64株, 血标本10株, 其他包括尿、咽拭子、分泌物等标本28株。标准菌株SA(ATCC 25923)作为纸片扩散法药敏试验的质控菌株。
2. 抗菌药物纸片及培养基 抗菌药物纸片分别为红霉素(15 μ g/片)、克林霉素(2 μ g/片)、头孢西丁(30 μ g/片), 均为英国Oxoid公司产品。血琼脂及水解酪蛋白胨琼脂(MH)平板购自上海伊华公司。
1. 细菌鉴定 标本送实验室后及时接种于血琼脂培养基上, 经35 ℃培养24 h。SA用VITEK GP板条进行鉴定。
2. 耐甲氧西林金黄色葡萄球菌(MRSA)的鉴定 按2009年美国临床实验室标准化协会(CLSI)标准操作[3], 将0.5麦氏单位SA的新鲜菌悬液均匀涂布于MH平板, 贴上头孢西丁(30 μ g)纸片, 35 ℃有氧环境孵育24 h观察结果, 测量抑菌环直径。SA:抑菌环直径≤ 19 mm为MRSA; 抑菌环直径≥ 20 mm为甲氧西林敏感金黄色葡萄球菌(MSSA)。
3. 克林霉素诱导耐药D试验 按照CLSI 2009版标准进行操作与判读[3]。挑选在35 ℃ 温箱内孵育1824 h的单个SA菌落, 配制成0.5麦氏单位菌悬液, 均匀涂布于MH平板上, 在相距15 mm处(边缘到边缘)分别贴上红霉素(15 μ g)和克林霉素(2 μ g)纸片。35 ℃孵育18~24 h后, 按红霉素14~22 mm, 克林霉素15~20 mm的标准判断。当克林霉素在靠近红霉素纸片一侧出现截平现象, 即克林霉素纸片的抑菌环看似大写的“ D” 时提示存在可诱导的克林霉素耐药, 即D试验阳性。若克林霉素抑菌环仍为圆形, 则D试验阴性。
4. 相关耐药基因的检测 模板的制备:挑取平板上单个菌落于TE 缓冲液混匀制成浊度为0.5 麦氏单位的悬液, 取细菌悬液100 μ L, 分别加入50 μ L细菌核酸裂解液, 混匀10 s; 100 ℃水浴10 min; 7600× g离心10 min, 取上清液作PCR扩增; PCR 扩增 扩增反应总体积为40 μ L, 其中10× PCR Buffer 4.0 μ L、dNTPs 0.8 μ L、MgCl3.2 μ L、上下游引物各0.5 μ L、0.3 μ L Taq DNA 聚合酶、DNA 模板4 μ L, 加水26.7 μ L; 寡核苷酸引物[4], 见表1。引物由上海生工生物工程有限公司合成; PCR条件:94 ℃预变性3 min, 94 ℃变性20 s, 57 ℃退火20 s, 72 ℃延伸45 s, 35个循环; 扩增产物分析 取10 μ L 扩增产物与2 μ L 上样缓冲液混匀后点样于含0.5 μ g 溴化乙锭的2 %琼脂糖凝胶, 120V 电泳40 min 后, 置入凝胶成像仪中观察并记录结果。
| 表1 寡核苷酸引物 |
146 株SA中MSSA 62株(42.5%), MRSA 84株(57.5%)。
SA对红霉素和克林霉素耐药分别为116 株和82 株, 分别占79.5%和56.2%。SA对红霉素及克林霉素同时耐药的有82株, 占56.2%。84株MRSA中, 未检出红霉素和克林霉素均敏感株, 红霉素和克林霉素均耐药的64株, 红霉素耐药而克林霉素敏感或中介的20株。62株MSSA对红霉素和克林霉素均敏感的30株, 对红霉素和克林霉素均耐药的18株, 对红霉素耐药而克林霉素敏感或中介的14株。2组均没有检测出红霉素敏感而克林霉素耐药的菌株, 见表2。
| 表2 MRSA、MSSA对红霉素和克林霉素不同耐药表型的菌株数(%) |
在SA中红霉素耐药而克林霉素敏感或中介的有34株, 其中D试验阳性26株, 红霉素诱导克林霉素耐药发生率76.5%(26/34), 见图1。MSSA 14株, D试验阳性10株, 红霉素诱导克林霉素耐药发生率71.4%(10/14)。MRSA 20株, D试验阳性16株, 红霉素诱导克林霉素耐药发生率80.0%(16/20), 见表3。
| 表3 SA中克林霉素诱导耐药发生 |
SA对大环内酯类抗菌药物的耐药机制有能量依赖的主动泵出和核糖体靶位改变2种[2]。前者由msrA基因编码外排蛋白导致对大环内酯类和链阳霉素的耐药, 对克林霉素敏感。后者由erm基因编码, 使得细菌核糖体50S 亚基23S rRNA特定核苷酸残基甲基化, 导致对具有相同靶位的大环内酯类、林可酰胺、链阳霉素B药物同时耐药, 临床称为MLS型耐药。耐药可分为结构型(cMLS)和诱导型(iMLS)。cMLS型耐药是指erm基因上游的启动子发生突变而使erm基因持续稳定表达产生耐药, 其表型为对红霉素和克林霉素均耐药, 常规的体外药敏试验均能测出。iMLS型耐药是指红霉素作为诱导剂可通过衰减机制诱导erm的表达而产生克林霉素耐药, 其表型为对红霉素耐药对克林霉素敏感。iMLS型耐药用常规药敏试验会造成漏检, 导致临床上的治疗失败。
在葡萄球菌中erm 基因目前发现了3 种, 即ermA、ermB 和ermC, ermA 和ermC 比较常见而ermB 则较少见报道。
本研究146株SA中, MRSA检出率 57.5%(84/146), MRSA比例的上升使SA对各种抗菌药物产生多重耐药。红霉素与克林霉素同时耐药在MRSA 和MSSA 中分别占76.2% (64 /84) 和29.0% (18 /62), 说明结构型耐药菌株在MRSA中较多见。对红霉素耐药而克林霉素敏感或中介的MRSA和MSSA分别是20株和14株, 其中D试验阳性的MRSA和MSSA分别为80.0% (16 /20)和71.4% (10 /14) , 即在红霉素耐药而克林霉素敏感或中介时有80.0%的MRSA和71.4%的MSSA对克林霉素具有诱导耐药性, 高于文献等[5, 6, 7]报道, 可能与不同地区细菌的红霉素耐药基因构成的差异有关。本实验146 株SA中, 克林霉素耐药菌株共108株, 占 73.9%。 其中结构型耐药82 株, 占56.2%, D试验阳性26 株, 占17.8%。结构型耐药菌株中MSSA占22.0 %(18/82)、MRSA占78.0%(64/82), D试验阳性菌株中MSSA占38.5%(10/26) MRSA占61.5%(16/26)。18 株显示结构型耐药的MSSA菌株中, 14株基因型为ermA, 4 株基因型为ermC, 未检出msrA基因型。10株显示诱导型耐药的MSSA菌株中7株基因型为ermC, 2 株基因型为ermA, 1株未检出任何基因型。64株显示结构型耐药的MRSA菌株中随机选取20株, 15株基因型为ermA, 5株基因型为ermC, 未检出msrA基因型。16株诱导型耐药的MRSA菌株中13株基因型为ermC, 3株基因型为ermA, 未检出同时带有2种基因的菌株。结构型耐药和诱导性耐药在MRSA中的比例均要比在MSSA中高, 说明MRSA比MSSA的耐药性更高、耐药范围更广, 但两者携带的主要结构耐药基因和诱导耐药基因没有差别, 均是ermA和ermC。因此, 克林霉素耐药菌株主要由erm基因决定, 结构型耐药菌株主要耐药基因为ermA , 其次是ermC, 诱导型耐药菌株的主要耐药基因为ermC。这同孙景勇[8]、 鲁卫平等[4]的报道基本一致。实验中1株D试验阳性的菌株未发现以上3种基因的任何1种, 可能是由其他基因如ermB 基因、msrB 基因等所导致的耐药而本实验未曾检测, 耐药机制尚需进一步研究确定。iMLS 型耐药的SA在临床上比较多见, 主要耐药基因为ermC, PCR方法可进行分子流行病学调查。稀释法药敏试验无法检测出可诱导的iMLS型耐药, 使用自动化仪器进行药敏试验的实验室更应注意克林霉素诱导耐药, 临床实验室应常规进行D试验, 避免临床不合理使用克林霉素。
The authors have declared that no competing interests exist.
| [1] |
|
| [2] |
|
| [3] |
|
| [4] |
|
| [5] |
|
| [6] |
|
| [7] |
|
| [8] |
|